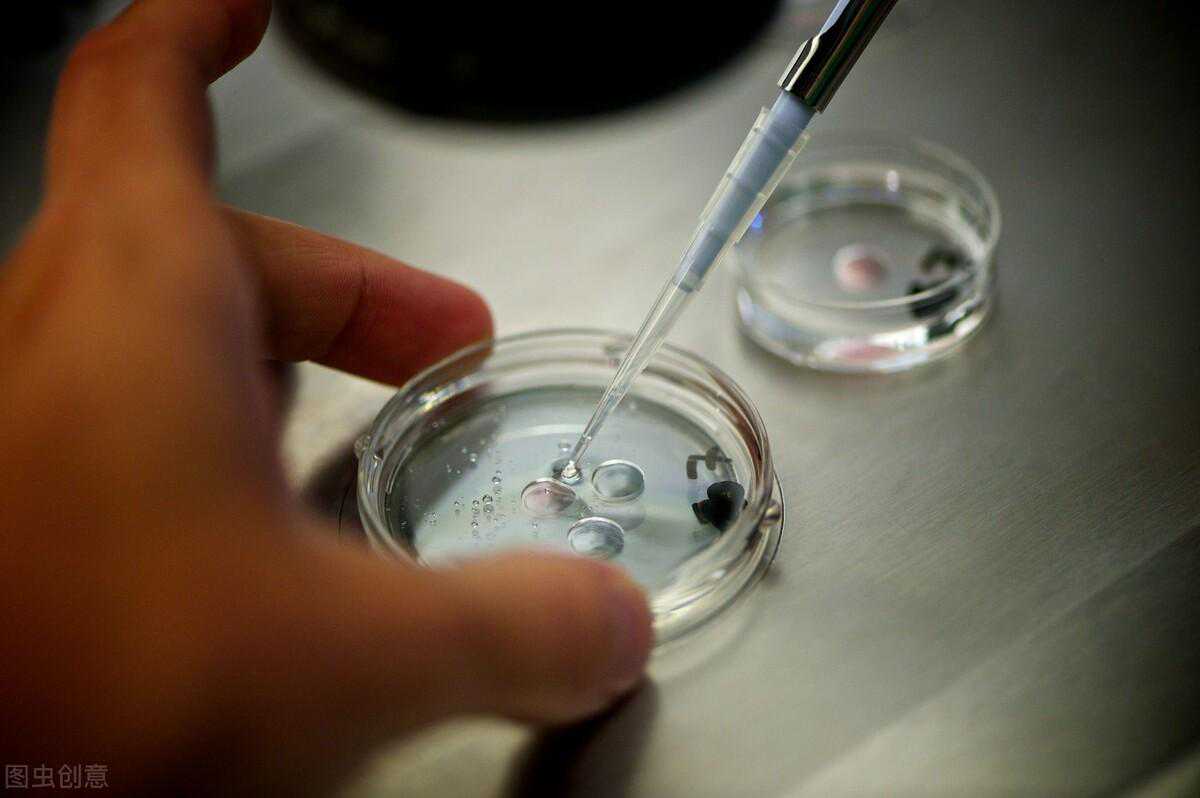

2020年6月15日,是我的取卵日,共取出了9颗卵,先生的精子也很好.取卵后回到家,喝了很多水,躺在床上休息。没有感觉到不适。肚子饿了,就喝了些猪肉青菜粥。接下来的几天我都吃得很清淡,没有做剧烈的运动,甚至家务活都没干,就是好好地休息.取卵后第5、6、7天肚子有点胀,我喝了很多水。之后就没什么事了。6月23日月经如期到来。
关于取卵之后遇到的问题,我个人认为还是个体的体质差异。总之,要多喝水,吃清淡流动的食物,休息好.取卵真的不可怕。取卵前,我多担心啊,怕取卵时会很疼,怕取卵后卵巢的不适症.结果,我都不知道什么时候卵子被取出了,醒来时已躺在休息室;取卵后,一切正常,除了三天时间的肚子小胀.

取卵前天肚子股股的和80支针头留下的痕迹
6月16日,中心来电,告诉我7颗卵成熟,6颗受精卵.我们还是很满意的.6月21日,中心来电,告诉我养成了4颗囊胚,将全部送去做PGT.心里暗暗高兴,4颗都正常的话,我一定要全部都生下来。6月30日,中心来电,告诉我们PGT结果回来了,有一颗正常的胚胎.我非常的难过,心里想的是4颗囊胚会正常的,结果却失望了。其它三颗囊胚的情况是:一颗多了17和18号染色体;一颗多了21号染色体,12号染色体缺了两片;一颗丢失了10号染色体,11号和16号染色体各缺一片。医生说我这个年纪,4个囊胚,1个健康,这种结果属于正常的。这也就是为什么做试管婴儿也要趁年轻的原因。高龄妇女的卵子老化,造成基因突变的情况增多.我想着再促排一次,可是母亲和先生都想先把这颗移植了。
接下来准备做子宫息肉手术。试管前期检查时,发现了我的子宫后壁是有粒小息肉的。同时我也开始服用避孕药为移植做准备。7月16日,我做了息肉手术,术后从麻醉药醒来后,明显感觉到小腹疼痛难受。护士给我服用了泰勒诺,交代我回家后如果继续疼,就要服用布洛芬。回家后,躺在床上休息了一下午,肚子没那么疼了。休息了几天,一切恢复正常.因为服用避孕药,断断续续会有血迹.8月4日,去见了主治医生,医生检查了下面,叫我把避孕药停了,让月经来.然后再等下次月经来时再准备服用三个星期的避孕药,再准备移植.她说就一颗卵,不要急,要确保子宫干净健康.
就这样,时间来到了10月份,现在的我正在为移植做准备.希望一切顺顺利利,明年可以抱个健健康康的牛宝宝.如果你也在试管的路上或准备试管,我们一起加油哦!!!!!!